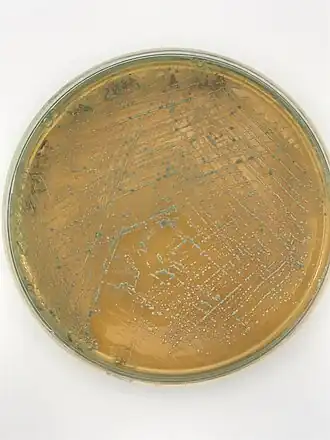

Pediococcus
Pediococcus
| |||||||||||||
|---|---|---|---|---|---|---|---|---|---|---|---|---|---|
![]() | |||||||||||||
| Classificação científica | |||||||||||||
| |||||||||||||
| Espécies | |||||||||||||
| P. acidilactici P. cellicola | |||||||||||||
Pediococcus Claussen, 1903 é um género de bactérias Gram-positivas produtoras de ácido láctico, incluídas na família Lactobacillaceae. As espécies pertencentes a este género ocorrem geralmente em aglomerados de dois ou quatro indivíduos, ou seja em pares ou tétradas, dividindo-se ao longo dos respectivos planos de simetria, comportamento que partilham com outros géneros de cocci produtores de ácido láctico, como Aerococcus e Tetragenococcus. As espécies pertencentes a este género são puramente homofermentativas. A espécie Pediococcus dextrinicus foi recentemente movida para o género Lactobacillus.[1]
Descrição e usos
As bactérias do género Pediococcus, em conjunto com outras espécies produtoras de ácido láctico como as pertencentes aos géneros Leuconostoc e Lactobacillus, são responsáveis pela fermentação de diversos alimentos para humanos e animais, como o sauerkraut e a silagem. Nesses processos de fermentação, os açúcares presentes nos vegetais frescos são fermentados em ácido láctico, o qual acidifica os produtos e impede a sua posterior degradação, retendo muito do seu valor nutricional.
As bactérias do género Pediococcus são geralmente consideradas como contaminantes em vinhos e cervejas, mas a sua presença é por vezes desejada em alguns estilos de cerveja, como o lambic.
Algumas estirpes de Pediococcus produzem diacetil, o composto que dá a alguns vinhos estilos de cerveja um aroma amanteigado ou do tipo butterscotch, como o Chardonnay.
Algumas espécies de Pediococcus são frequentemente usadas como inoculantes no processo de ensilagem e como probióticos, sendo considerados micróbios benéficos na produção de queijos e iogurtes.
Ver também
- Firmicutes
- Lactobacillus
- Pediococcus acidilactici
- Sauerkraut
Notas
- ↑ Haakensen, M; Dobson, CM; Hill, JE; Ziola, B (2009). «Reclassification of Pediococcus dextrinicus (Coster and White 1964) back 1978 (Approved Lists 1980) as Lactobacillus dextrinicus comb. Nov., and emended description of the genus Lactobacillus». International journal of systematic and evolutionary microbiology. 59 (Pt 3): 615–21. PMID 19244449. doi:10.1099/ijs.0.65779-0